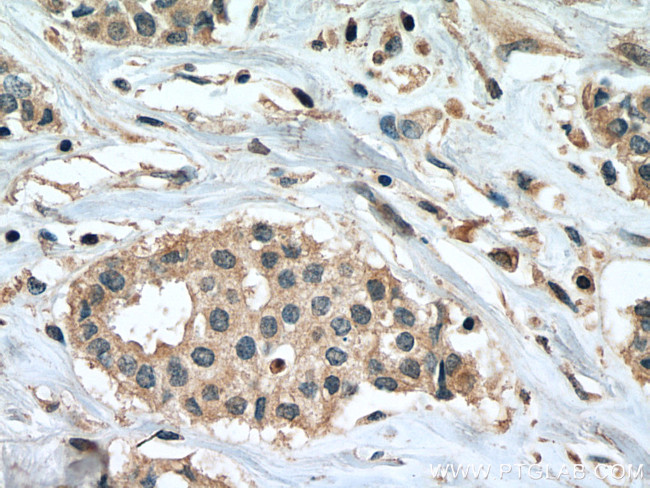
PPM1B Antibody in Immunohistochemistry (Paraffin) (IHC (P))

Search
Proteintech
PPM1B Monoclonal Antibody (2C7H2)
{{$productOrderCtrl.translations['antibody.pdp.commerceCard.promotion.promotions']}}
{{$productOrderCtrl.translations['antibody.pdp.commerceCard.promotion.viewpromo']}}
{{$productOrderCtrl.translations['antibody.pdp.commerceCard.promotion.promocode']}}: {{promo.promoCode}} {{promo.promoTitle}} {{promo.promoDescription}}. {{$productOrderCtrl.translations['antibody.pdp.commerceCard.promotion.learnmore']}}
产品信息
67647-1-IG
种属反应
宿主/亚型
分类
类型
克隆号
抗原
偶联物
形式
浓度
纯化类型
保存液
内含物
保存条件
运输条件
产品详细信息
Aliquoting is unnecessary for -20°C storage.
靶标信息
The protein encoded by this gene is a member of the PP2C family of Ser/Thr protein phosphatases. PP2C family members are known to be negative regulators of cell stress response pathways. This phosphatase has been shown to dephosphorylate cyclin-dependent kinases (CDKs), and thus may be involved in cell cycle control. Overexpression of this phosphatase is reported to cause cell-growth arrest or cell death. Alternative splicing results in multiple transcript variants encoding different isoforms. Additional transcript variants have been described, but currently do not represent full-length sequences.
仅用于科研。不用于诊断过程。未经明确授权不得转售。
篇参考文献 (0)
生物信息学
蛋白别名: PP2C-beta; Protein phosphatase 1B; protein phosphatase 1B (formerly 2C), magnesium-dependent, beta isoform; Protein phosphatase 2C isoform beta; protein phosphatase 2C-like protein; protein phosphatase, Mg2+/Mn2+ dependent, 1B; Ser/Thr protein phosphatase type 2C beta 2 isoform
基因别名: PP2C-beta; PP2C-beta-X; PP2CB; PP2CBETA; PPC2BETAX; PPM1B
UniProt ID: (Human) O75688
Entrez Gene ID: (Human) 5495